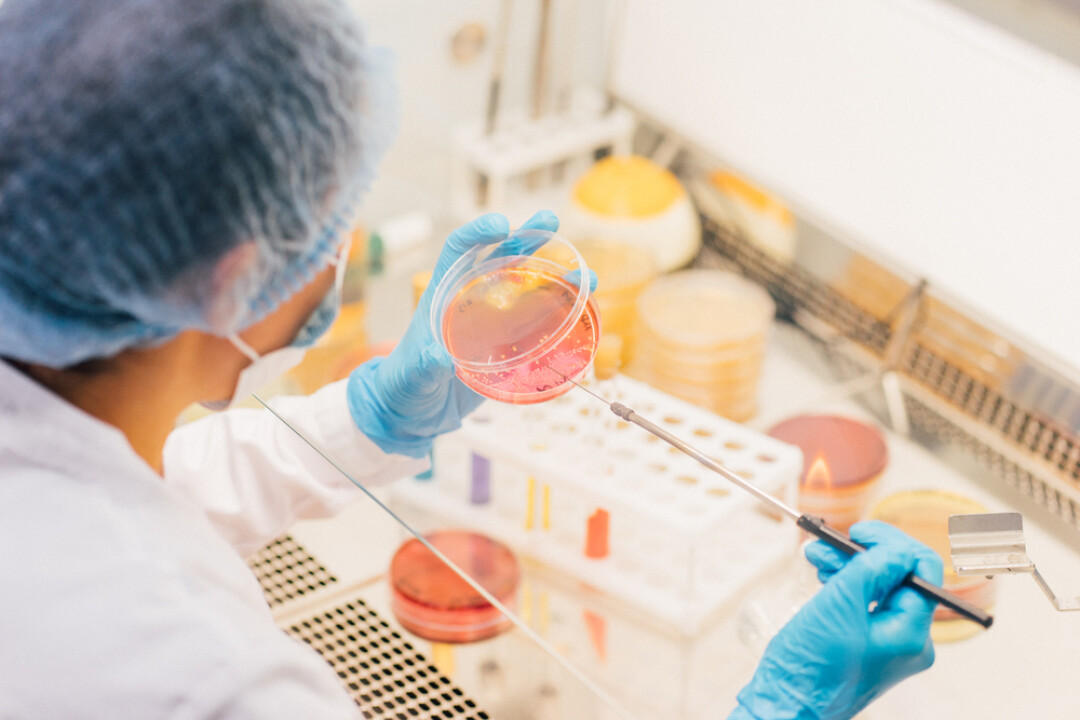

Если раньше готовая еда была палочкой-выручалочкой в первую очередь для сотрудников офисов и студентов, то во времена пандемии, когда многие кафе и рестораны оказались закрыты, доставку полноценных блюд активно начали предлагать и ритейлеры. Под собственными торговыми марками они выпускали целые линейки готовой продукции, начиная от закусок и заканчивая вторыми блюдами. Постепенно готовая еда стала частью нашей повседневной жизни, а ее ассортимент оказался гораздо разнообразнее домашнего меню и иногда даже выгоднее. Мы и сами частенько заходим в ближайший магазин «Пятёрочки» за готовыми завтраками или покупаем салаты, когда ждем гостей. Это вкусно, но мы решили узнать, как именно они создаются.
Раз уж мы упомянули «Пятёрочку», то решили выяснить это на ее примере. Из годового отчета за 2022 год, мы узнали, что доля продажи готовой еды в сети магазинов выросла на 40% относительно 2021 года. «Пятёрочка» выпускает большое количество готовых блюд под брендами «Пятёрочка Кафе» и «Рестория Шеф» — более 300 видов салатов, основных блюд, сэндвичей и роллов, корейских закусок и завтраков. Их производят на принадлежащей Х5 Group фабрике-кухне в Подмосковье и доставляют не только в московские магазины, но и петербургские, воронежские, новгородские — те, которые находятся в радиусе 600 км, чтобы блюда были максимально свежими. Мы договорились об экскурсии на фабрику, чтобы выяснить, как и из чего делают наш любимый оливье и сырники.
Фабрика-кухня
Пасмурное раннее февральское утро. В метро еще даже не час пик, а на улице не рассвело. Едем в сторону города Долгопрудный, где находится фабрика-кухня X5 Ready Food. Здесь круглосуточно кипит работа, обеспечивая непрерывность и цикличность производства. Более 1000 человек в тесной связке с машинами, в четыре смены готовят еду, которая фасуется в контейнеры, коробки и пакеты, чтобы всего через несколько часов оказаться на полках магазинов в разделе готовой еды.
Нас встречает Игорь Старосельский, директор пищевого производства, который и станет нашим проводником на кухню, во всех смыслах этого слова. Слушаем инструкции по безопасности, снимаем все украшения, надеваем бахилы, халаты, шапочки и перчатки, проходим несколько этапов санобработки, как и все сотрудники фабрики-кухни, и заходим внутрь.
Маршрутная карта
Фабрика открылась в 2019 году, а через год началась пандемия. Процесс тут сразу организовали таким образом, чтобы работники разных цехов даже не пересекались друг с другом, поэтому каждый этап производства отделен от другого. Итак, сначала оказываемся на складе сырья и материалов. Дальше проходим камеры суточного запаса, склады сыпучих продуктов и камеры ультрафреша, где хранятся овощи. Затем попадаем в полуфабрикатные цеха, где происходит мариновка и формовка. Дальше проходим в горячий цех, где заготовки жарятся, парятся, запекаются или готовятся по технологии су-вид. Идем мимо камер временного хранения продуктов, которые используются для приготовления салатов и сэндвичей. И попадаем в цех упаковки. После упаковки готовая продукция поступает в зону временного ожидания отгрузки. Мы были на фабрике-кухне утром, а в 6 часов вечера склад очистится под ноль, и вновь заполнится следующей партией продукции. Еда доставляется в магазины в течение суток со строгим соблюдением температурных режимов, так блюда остаются свежими на полках более семи дней. Как и все товары, готовая еда по истечении срока годности утилизируется.
Сырье и хранение
Игорь Старосельский рассказывает, что за счет постоянной ротации на фабрике-кухне риски потерь и списаний сырья минимальны, все четко рассчитано. Все входящее сырье проходит лабораторный контроль: оно поступает на склад в ячейку хранения и блокируется на контроле качества до тех пор, пока сотрудники лаборатории не проведут все необходимые исследования и не пропустят сырье в свободное использование. С поставщиками работают напрямую, например, овощи выращивают специально под объемы X5, учитывая нужные сорта и спецификации (даже помидоры черри отбираются определенного калибра). Что касается хранения продуктов, тут тоже все очень строго. Если камера хранения не будет закрыта или в ней будет нарушен температурный режим, срабатывает очень громкая сигнализация, которую слышат все. Тогда на площадке появляются сотрудники контроля качества, выборочно берут сырье из этой камеры и удостоверяются, что оно не пострадало. Но если какие-то изменения уже начались, то происходит списание всех продуктов и содержимое камеры заменяется на новое. Со слов Игоря, подобных ситуаций, к счастью, не происходило. Конечный продукт тоже проверяется на соответствие качеству, и только потом попадает на полки магазинов.
Ручной труд
На фабрике-кухне много ручного труда, и это может показаться удивительным, но на деле все объясняется очень просто. Когда продукт многокомпонентный, справиться с его приготовлением может только человек, машины пока к этому не приспособлены. Сырники, куколки для котлет по-киевски и многое другое делается вручную, то есть с душой. Что касается сырников, более 40 тысяч штук проходят через руки сотрудников цеха в день. Фасовка готовых салатов или горячих блюд тоже происходит вручную, потому что на одной и той же линии могут проходить упаковку совершенно разные продукты и было бы сложно постоянно перенастраивать механизмы. А еще запайкой этих продуктов в контейнеры занимается машина с очень чувствительной граммовкой, и только человек может отследить, чтобы в каждой таре была погрешность не более 2% или 4 граммов. «Люди здесь работают с опытом, и вы не найдете того, кто приходит на работу просто за зарплатой, то есть каждый сотрудник очень вовлечен», — отмечает Игорь Старосельский.
«Золотые рецептуры»
За создание рецептов отвечает команда R&D, во главе с руководителем направления, Игорем Голубовским. Его команда разрабатывает каждое блюдо с нуля на основе классической рецептуры и авторских ноу-хау. Все сотрудники, которые работают на фабрике понимают, что на одной сковороде можно сделать все что угодно, но дальше рецепт нужно будет масштабировать, а это уже совершенно другой принцип приготовления. После того как блюдо готово, оно попадает к экспертам Студии вкуса «Пятёрочки». Здесь блюда оценивают с точки зрения гостей магазинов: их проверяют на вкус, свежесть, удобство в использовании и соответствие ожиданиям.
Игорь Старосельский отмечает: «Внутри России есть четкое понимание того, что мода и тренды приходят из Петербурга, я думаю, это связано с близостью к Европе. И тот, кто может предугадать на три года вперед, что зайдет в Петербурге, тот и есть законодатель мод. Безусловно, бывают и исключения, когда мода приходит с других направлений, например, фо-бо, который сначала появился в Москве. При этом у нас нет цели сделать для каждого региона что-то уникальное, мы решаем другую задачу. Наша основная сила в том, что мы создаем “золотые рецептуры”, которые потом применимы на любом региональном рынке. Селедка под шубой и оливье — это must-have, которые были, есть и будут всегда. Основное направление нашей работы сейчас — это улучшение качества, вкуса и состава готовых блюд».
Обратная связь
Кроме того, мы узнали, что «Пятëрочка» собирает обратную связь от гостей через приложение сети. Блюда, которые получают среднюю оценку ниже 4,7 баллов, автоматически отправляются на доработку. Есть уже много кейсов, когда потребители помогли сети обнаружить недоработки и улучшить продукт. Например, гости магазинов попросили изменить рецептуру рулетов из баклажанов и сделать их начинку менее жирной и тяжелой. На фабрике-кухне стали тоньше нарезать баклажан, увеличили время обжарки и переделали начинку. В итоге все остались довольны.
Собственное производство позволяет не только контролировать качество и вкус продукта на всех этапах, но и реализовывать его по более низкой цене, что тоже немаловажно для нас, покупателей.
После этого мини-расследования доверия к готовой еде стало гораздо больше. Не зря она пользуется таким спросом и, конечно, впечатляет то, что можно оставить отзыв, который действительно влияет на качество продукта.

Комментарии (0)